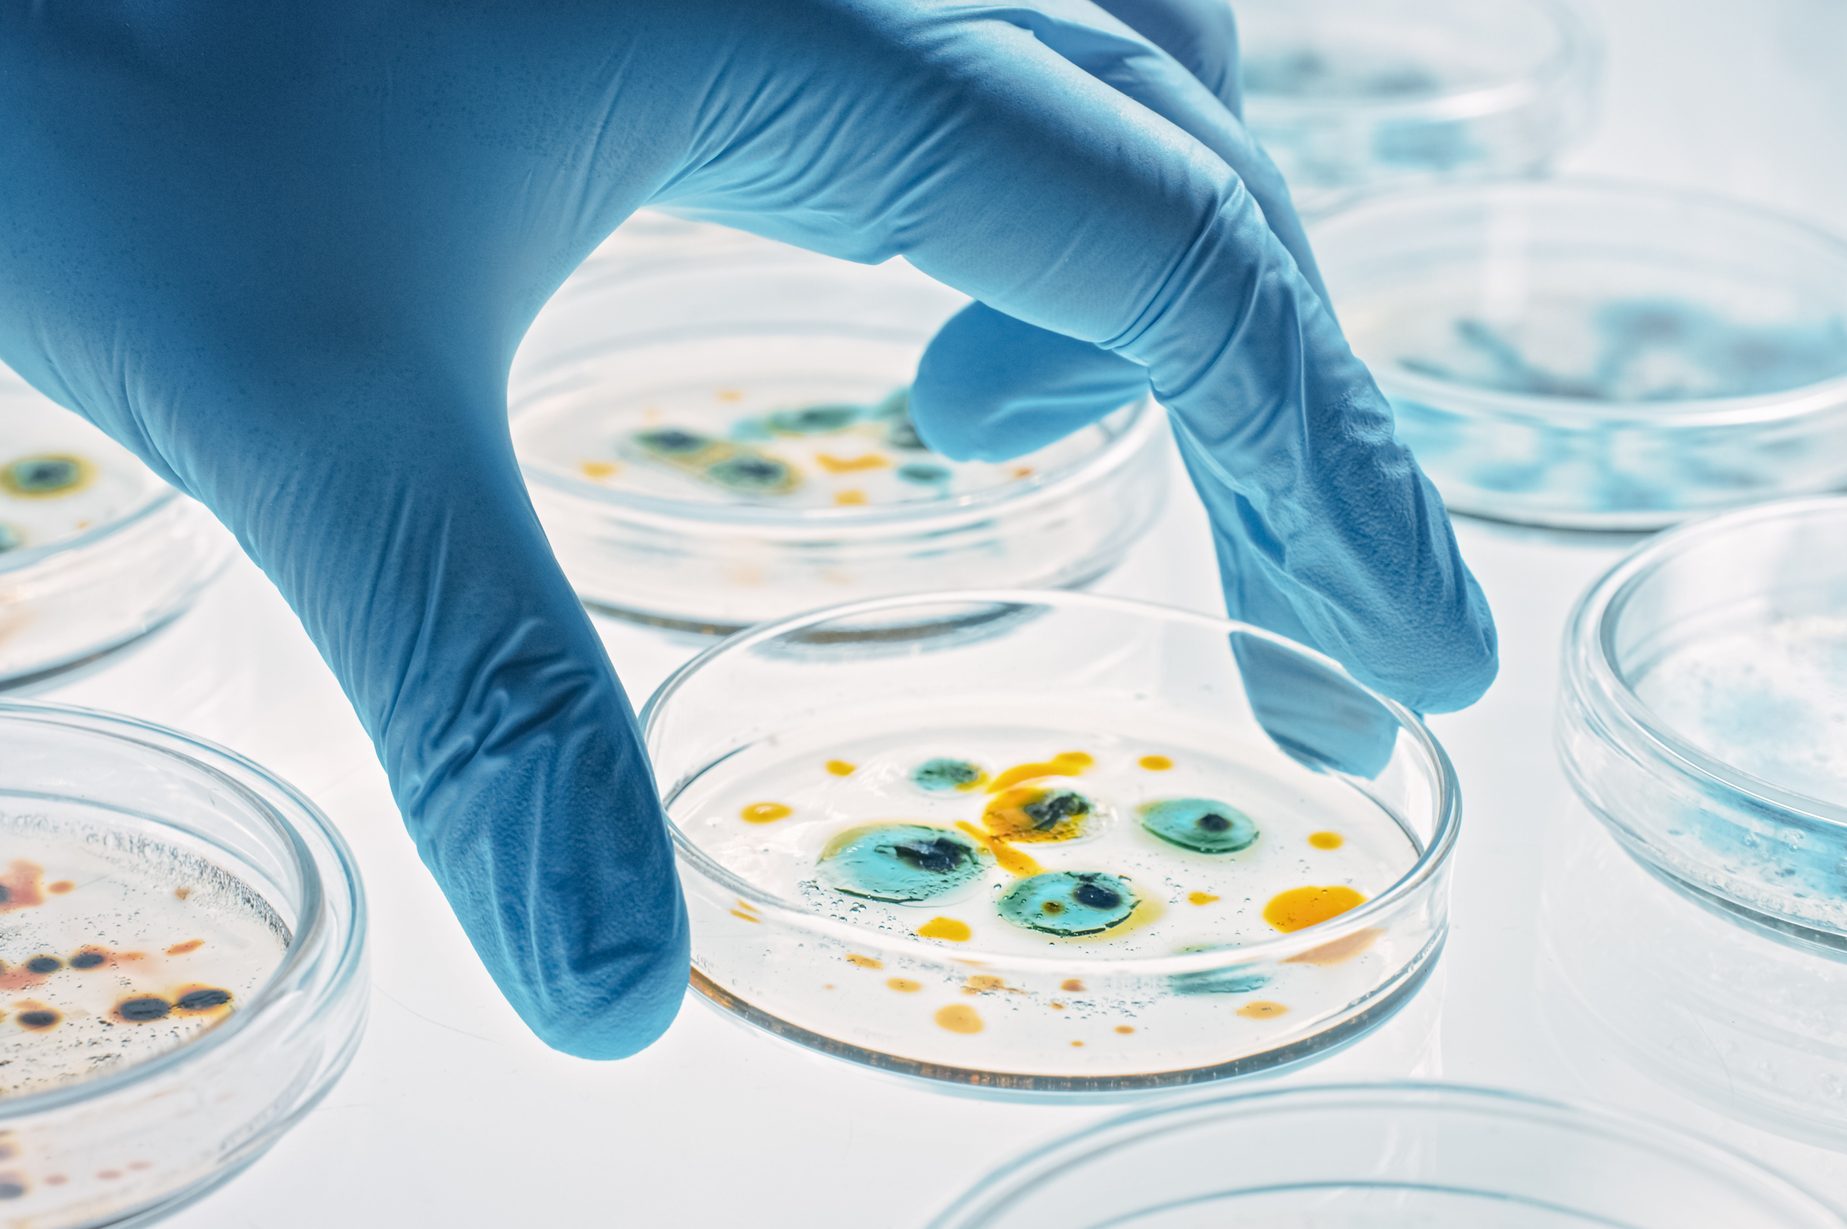
Scientist Works with Petri Dishes with Various Bacteria, Tissue and Blood Samples. Concept of Pharmaceutical Research for Antibiotics, Curing Disease with DNA Enhancing Drugs. Moving Close-up Macro

St. Patrick's Day and Women's History Month are only a few of the March holidays to celebrate in 2025!

March Holidays and Observances to Celebrate Year After Year

In March we welcome spring, along with a tapestry of traditional and unexpected celebrations fit for this (hopefully) warmer month. March holidays include St. Patrick’s Day, a lively affair full of emerald-green festivities, and Women’s History Month, where we spotlight the amazing contributions of women throughout history. And unlike last year, Easter takes a leap forward into March for 2025, adding an early dose of joy and renewal for the month, and the spring.
Overall, the month of March is full of surprising and fun monthly, weekly and daily observances, from Chocolate Chip Cookie Week and International Rescue Cat Day to Popcorn Lover’s Day and World Poetry Day too! Plus, have you heard of Wear a Hat Day? If you’re looking to celebrate the known and lesser-known March holidays this year, look to our list below.
Get Reader’s Digest’s Read Up newsletter for more holidays, fun facts, humor, cleaning, travel and tech all week long.
What are the popular March holidays?
Popular March holidays in 2025 include Women’s History Month and St. Patrick’s Day (Irish American Heritage Month too!). Mardi Gras is also happening this month in 2025!
Monthly March holidays

- Adopt a Rescued Guinea Pig Month
- American Red Cross Month
- Berries and Cherries Month
- Brain Injury Awareness Month
- Developmental Disabilities Awareness Month
- Dolphin Awareness Month
- Endometriosis Awareness Month
- Expanding Girls’ Horizons in Science and Engineering Month
- International Ideas Month
- Irish American Heritage Month
- Listening Awareness Month
- Mad for Plaid Month
- Multiple Sclerosis Awareness Month
- National Athletic Training Month
- National Brain Injury Awareness Month
- National Celery Month
- National Cerebral Palsy Awareness Month
- National Cheerleading Safety Month
- National Color Therapy Month
- National Craft Month
- National Crochet Month
- National Deaf History Month
- National Flour Month
- National Frozen Food Month
- National Kidney Month
- National Music in Our Schools Month
- National Noodle Month
- National Nutrition Month
- National Optimism Month
- National Peanut Month
- National Reading Month
- National Social Work Month
- National Umbrella Month
- National Women’s History Month
Weekly March holidays
- Sea Week (March 2–10)
- Chocolate Chip Cookie Week (March 3–9)
- Women in Construction Week (March 3–9)
- Women of Aviation Worldwide Week (March 4–10)
- National Aardvark Week (March 4–10)
- Girl Scout Week (March 10–16)
- National Agriculture Week (March 17–23)
- National Anonymous Giving Week (March 17–23)
- National Introverts Week (March 18–24)
- National Cleaning Week (March 24–30)
- National Tsunami Awareness Week (March 24–30)
Daily March holidays in 2025
March 1

- Baby Sleep Day
- Employee Appreciation Day
- National Black Women in Jazz and the Arts Day
- National Horse Protection Day
- National Peanut Butter Lover’s Day
- National Pig Day
- National Play Outside Day
- National Wedding Planning Day
- National Welsh Corgi Day
- Plan a Solo Vacation Day
- Share a Smile Day
- World Compliment Day
- World Music Therapy Day
- World Seagrass Day
March 2
- Dr. Seuss’s Birthday
- International Rescue Cat Day
- National Banana Cream Pie Day
- National Old Stuff Day
- National Read Across America Day
- World Teen Mental Wellness Day
March 3
- National Anthem Day
- National Day of Unplugging
- National Mulled Wine Day
- World Hearing Day
- World Wildlife Day
March 4

- Marching Music Day
- Mardi Gras
- National Backcountry Ski Day
- National Dance the Waltz Day
- National Grammar Day
- National Pound Cake Day
- National Snack Day
- National Sons Day
- World Obesity Day
March 5
- National Cheese Doodle Day
March 6
- National Dentists Day
- National Dress Day
- National Frozen Food Day
- National Oreo Cookie Day
- National White Chocolate Cheesecake Day
- World Tennis Day
March 7
- National Cereal Day
- National Flapjack Day
- Sock Monkey Day
March 8
- Discover What Your Name Means Day
- International Women’s Day
- National Peanut Cluster Day
- National Proofreading Day
- National Retro Video Game Day
March 9
- National American Paddlefish Day
- National Barbie Day
- National Get Over It Day
- National Meatball Day
- Popcorn Lover’s Day
March 10

- Daylight Savings
- Harriet Tubman Day
- International Bagpipe Day
- Middle Name Pride Day
- National Dry Shampoo Day
- National Mario Day
- National Pack Your Lunch Day
- National Women and Girls HIV/AIDS Awareness Day
- Skirt Day
March 11
- International Fanny Pack Day
- National Johnny Appleseed Day
- National Napping Day
- National Oatmeal Nut Waffles Day
- National Promposal Day
- World Plumbing Day
March 12
- Girl Scouts’ Birthday
- National Plant a Flower Day
- National Working Moms Day
March 13
- National Coconut Torte Day
- National Earmuff Day
- National Good Samaritan Day
- National Jewel Day
- National K9 Veterans Day
March 14
- Celebrate Scientists Day
- International Day of Mathematics
- National Children’s Craft Day
- National Equal Pay Day
- National Learn About Butterflies Day
- National Organize Your Home Office Day
- National Pi Day
- National Potato Chip Day
- National Save a Spider Day
- National Write Your Story Day
- Science Education Day
- World Kidney Day
March 15
- Ides of March
- World Sleep Day
March 16
- National Artichoke Day
- National Corn Dog Day
- National Freedom of Information Day
- National Panda Day
- National Quilting Day
- National Vaccination Day
March 17
- National Corned Beef and Cabbage Day
- National Preschool Teacher Appreciation Day
- St. Patrick’s Day
March 18
- Global Recycling Day
- International Sports Car Racing Day
- National Awkward Moments Day
- National Sloppy Joe Day
- Save the Florida Panther Day
- Transit Driver Appreciation Day
March 19

- International Read to Me Day
- National Agriculture Day
- National Backyard Day
- National Certified Nurses Day
- National Chocolate Caramel Day
- National Let’s Laugh Day
- National Poultry Day
- Spring Equinox
March 20
- International Day of Happiness
- National Proposal Day
- National Quilting Day
- National Ravioli Day
- Spring Equinox
- World Flour Day
- World Oral Health Day
- World Storytelling Day
March 21
- International Color Day
- International Day of Forests
- National Common Courtesy Day
- National Crunchy Taco Day
- National Fragrance Day
- National French Bread Day
- National Healthy Fats Day
- National Memory Day
- National Renewable Energy Day
- National Rosie the Riveter Day
- National Single Parent Day
- World Down Syndrome Day
- World Poetry Day
March 22
- American Red Cross Giving Day
- International Day of the Seal
- International Talk Like William Shatner Day
- National Goof Off Day
- World Water Day
March 23

- Cuddly Kitten Day
- National Chia Day
- National Chip and Dip Day
- National Puppy Day
- National Tamale Day
- Purim
- World Meteorological Day
March 24
- National Cheesesteak Day
- National Chocolate-Covered Raisin Day
- National Cocktail Day
- Palm Sunday
- World Tuberculosis Day
March 25
- Holi
- Tolkien Reading Day
- Waffle Day
- Walk in the Sand Day
March 26
- Epilepsy Awareness Day
- Make Up Your Own Holiday Day
- National Spinach Day
- Solitude Day
- Wear a Hat Day
March 27

- Manatee Appreciation Day
- National Scribble Day
- National Spanish Paella Day
- World Theatre Day
March 28
- National Black Forest Cake Day
- National Hot Tub Day
- National Something on a Stick Day
- Respect Your Cat Day
March 29
- International Mermaid Day
- National Mom-and-Pop Business Owners Day
- National Pita Day
- National Vietnam War Veterans Day
- Ramadan ends
- World Piano Day
March 30
- National Doctors’ Day
- National Folding Laundry Day
- National Pencil Day
- National Virtual Vacation Day
- Take a Walk in the Park Day
- World Bipolar Day
March 31
- Crayola Crayon Day
- Eiffel Tower Day
- International Transgender Day of Visibility
- National Farm Workers Day
- National Prom Day
- National Tater Day
Next, learn more about some of these unique spring celebrations.























